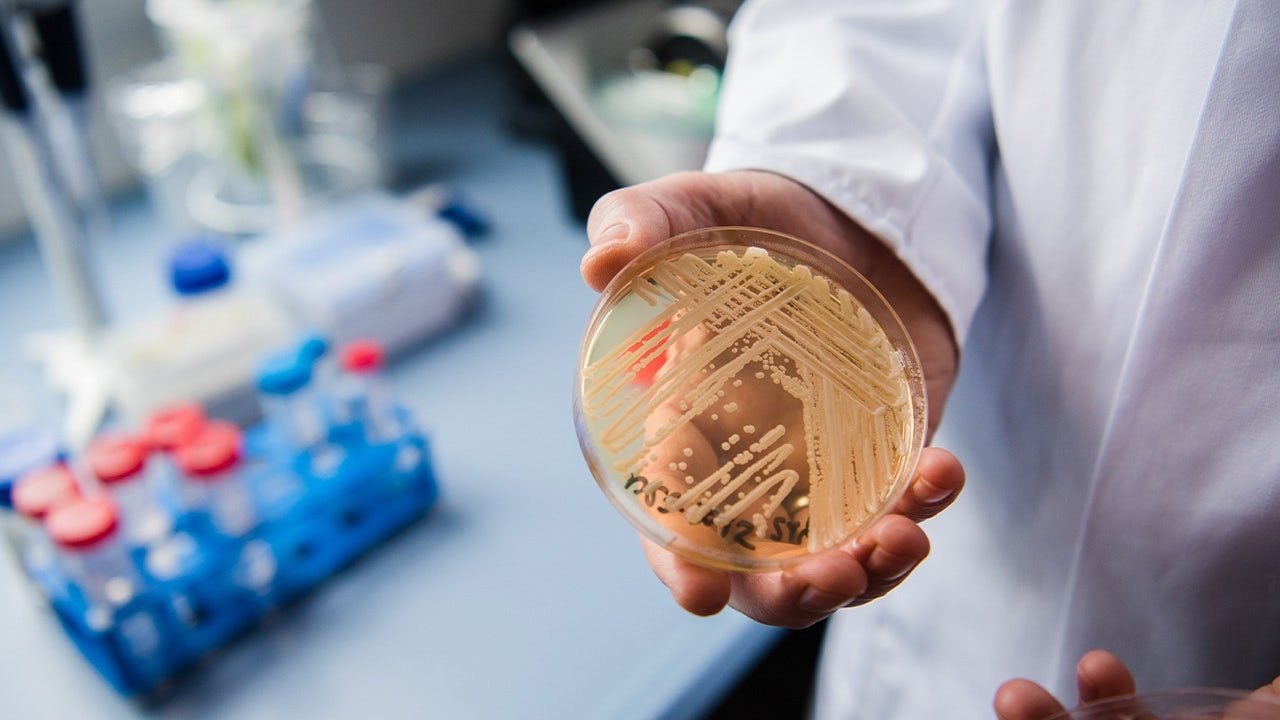

Un hongo altamente peligroso y resistente a los tratamientos médicos se está propagando con rapidez en hospitales de Estados Unidos y otros países, encendiendo nuevas alertas entre especialistas en salud pública, según una reciente revisión científica.
El patógeno, identificado como Candida auris, ha demostrado una capacidad creciente para evadir el sistema inmunológico humano y resistir múltiples fármacos, de acuerdo con investigadores del Centro para el Descubrimiento y la Innovación de Hackensack Meridian. El estudio fue publicado a comienzos de diciembre y refuerza la preocupación internacional en torno a esta amenaza emergente.
Las conclusiones coinciden con advertencias previas de los Centros para el Control y la Prevención de Enfermedades (CDC), que clasifican a C. auris como una amenaza antimicrobiana urgente. Datos del organismo indican que solo en 2025 se detectaron cerca de 7.000 casos en decenas de estados estadounidenses, principalmente en hospitales y centros de cuidados prolongados. El hongo ya ha sido identificado en al menos 60 países.
Un patógeno difícil de contener
A diferencia de otros hongos, Candida auris puede persistir en la piel humana y adherirse con facilidad a superficies y equipos médicos, lo que favorece su transmisión en entornos sanitarios. Además, presenta una elevada resistencia a los tratamientos disponibles.
“Es un hongo resistente a múltiples medicamentos antimicóticos y tiende a propagarse con facilidad dentro de hospitales”, explicó el doctor Marc Siegel, profesor clínico de medicina en NYU Langone, en declaraciones a Fox News.
Retos y posibles soluciones
Pese al escenario preocupante, los investigadores destacan oportunidades para enfrentar la amenaza. La revisión científica subraya la necesidad de desarrollar nuevos antifúngicos de amplio espectro, mejorar los métodos de diagnóstico y avanzar en vacunas y terapias basadas en la respuesta inmunológica.
Especialistas advierten que el control de Candida auris requerirá estrategias coordinadas de vigilancia, prevención y desarrollo científico, ante un patógeno que continúa expandiéndose y adaptándose a los sistemas de salud modernos.